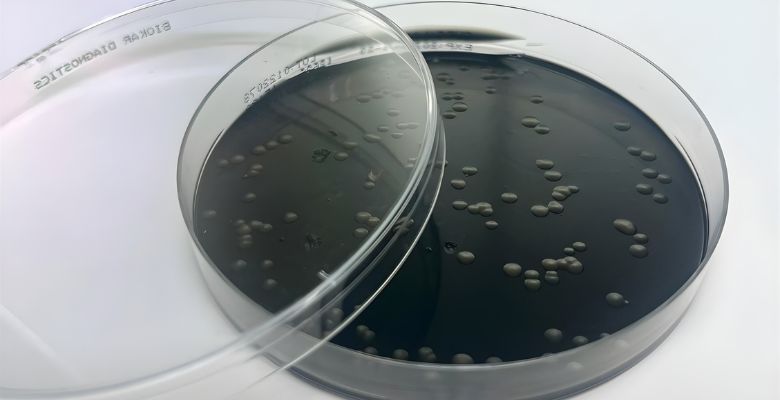

Carolina Vieira
Investigadora do CBR vai decifrar mecanismos de infeção por parasita Trypanosoma vivax com bolsa europeia
A investigadora do Centro de Investigação Biomédica (CBR) da Faculdade de Medicina da Universidade Católica Portuguesa, Carolina Vieira, conquistou uma bolsa pós-doutoral Marie Skłodowska-Curie (MSCA), sendo uma das cerca de 40 atribuídas a instituições de acolhimento em Portugal. O projeto visa desvendar os mecanismos de infeção de parasitas do género…